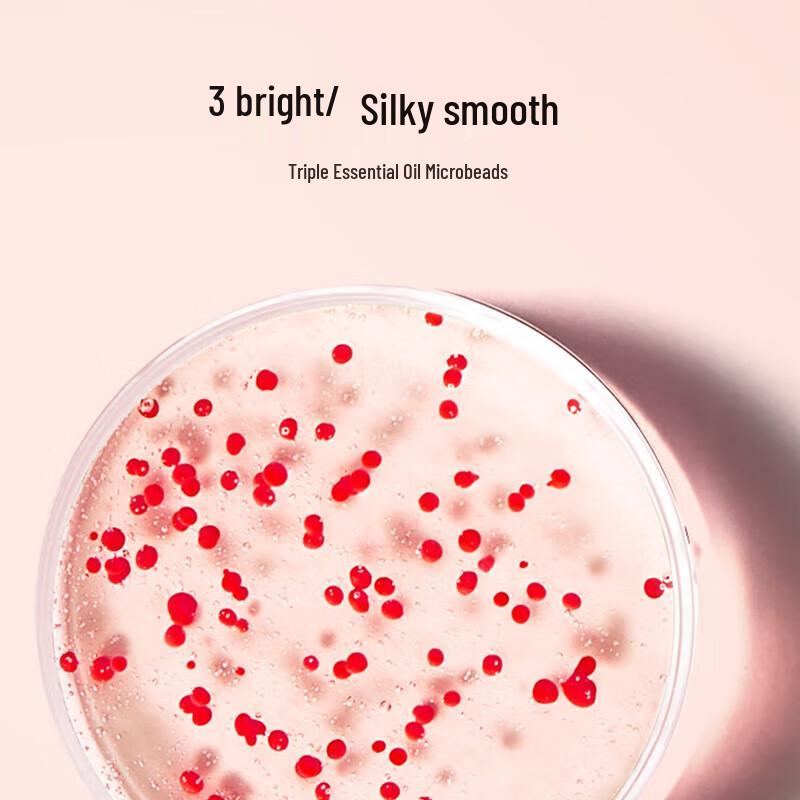
René Furterer Strengthening & Volumizing Shampoo

Site-ul nu acceptă browserul dvs. Vă rugăm să actualizați browserul sau să descărcați altul
René Furterer Strengthening & Volumizing Shampoo
Prețul curent
Preț 113,40 RONinclusiv TVA

Model
Livrare în 🇷🇴 România
7–15 zile lucrătoare · 35 RON per comandă
Plățile și confidențialitatea ta sunt în siguranță







Siguranța și conformitatea produsului
Caracteristici
Efectul utilizării
reduce căderea părului
Descriere
JDST online
4,5/3.000+